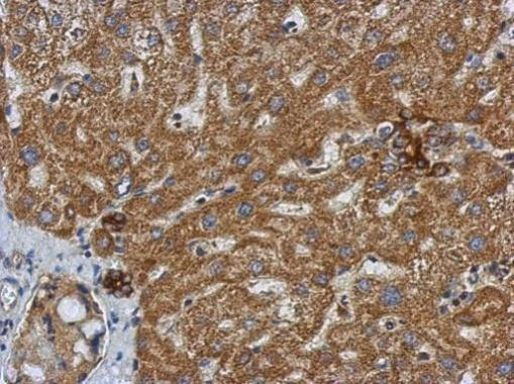
SMYD3 Antibody in Immunohistochemistry (Paraffin) (IHC (P))

Search
Invitrogen
SMYD3 Polyclonal Antibody
{{$productOrderCtrl.translations['antibody.pdp.commerceCard.promotion.promotions']}}
{{$productOrderCtrl.translations['antibody.pdp.commerceCard.promotion.viewpromo']}}
{{$productOrderCtrl.translations['antibody.pdp.commerceCard.promotion.promocode']}}: {{promo.promoCode}} {{promo.promoTitle}} {{promo.promoDescription}}. {{$productOrderCtrl.translations['antibody.pdp.commerceCard.promotion.learnmore']}}
产品信息
PA5-31920
宿主/亚型
分类
类型
抗原
偶联物
形式
浓度
规格
保存条件
运输条件
RRID
产品详细信息
PA5-31920 targets SMYD3 in IHC (P) and WB applications and shows reactivity with Human samples.
The PA5-31920 immunogen is recombinant protein fragment corresponding to a region within amino acids 201 and 411 of Human SMYD3.
靶标信息
SMYD3 (histone-lysine N-methyltransferase) methylates Lys-4 of histone H3 and Lys-5 of histone H4. It induces di- and tri-methylation. SMYD3 plays an important role in transcriptional activation as a member of an RNA polymerase complex.
⚠WARNING: This product can expose you to chemicals including mercury, which is known to the State of California to cause birth defects or other reproductive harm. For more information go to www.P65Warnings.ca.gov.
仅用于科研。不用于诊断过程。未经明确授权不得转售。